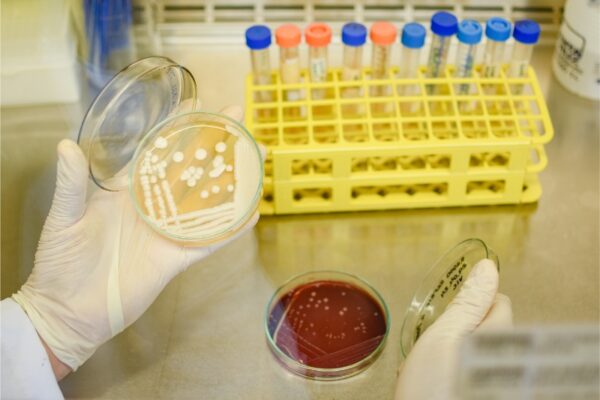

Laboratórios
A Universidade Federal do Agreste de Pernambuco (UFAPE) dispõe de uma avançada infraestrutura laboratorial multiusuária que apoia as atividades de ensino, pesquisa e extensão dos cursos de graduação e pós-graduação nas áreas das Ciências Agrárias.
Organizados em cinco seções — Apoio à Pesquisa (SLAP), Ensino (SLE), Anatomia e Patologia Animal (SLAPA), Ciência e Tecnologia de Alimentos (SLCTAL) e Pós-Graduação (SLP) —, esses laboratórios são fundamentais para a formação prática dos estudantes, integrando atividades de aulas, pesquisa e extensão, incluindo aquelas desenvolvidas pelo corpo docente e discente do PPGSA.
Laboratório de Anatomia e Patologia Animal – LAPA
No Laboratório de Anatomia e Patologia Animal (LAPA) são realizadas atividades de dissecação e outras técnicas de conservação de cadáveres de animais, estudos morfológicos, além de necropsias, processamento e diagnóstico histopatológico.
Responsável: Profa. Emanuela Polimeni de Mesquita
contato: emanuela.polimeni@ufape.edu.br
Laboratório de Biologia Molecular
O Laboratório multiusuário de Biologia Molecular apoia atividades de pesquisa e ensino, tanto da graduação quanto da pós-graduação. Nesse Laboratório são realizadas atividades de extração e purificação de ácidos nucléicos, assim como a análise de genes pela amplificação de DNA através da técnica de PCR e visualização de amplicons por eletroforese.
Responsáveis: Prof. Marcelo Mendonça/Profa. Elizabete Rodrigues da Silva
Contato: marcelo.mendonca@ufape.edu.br/elizabete.rodrigues@ufape.edu.br
Laboratório de Microbiologia Animal
No Laboratório de Microbiologia Animal (LabMicro) são realizadas atividades de isolamento, identificação e caracterização de patógenos de interesse para a medicina veterinária, com destaque para os agentes bacterianos causadores de mastite em animais de produção.
Responsável: Profa. Elizabete Rodrigues da Silva
Contato: elizabete.rodrigues@ufape.edu.br
Laboratório de Microbiologia, Tecnologia Enzimática e Bioprodutos
O Laboratório de Microbiologia, Tecnologia Enzimática e Bioprodutos (LMTEB) abriga as atividades de três grupos de pesquisa distintos, incluindo o Grupo de Pesquisa em Substâncias Bioativas de Origem Natural e Sintética. Este grupo é focado no estudo da química de compostos com potencial farmacológico e tóxico, contribuindo para o avanço científico na área de produtos bioativos. As atividades desenvolvidas incluem a síntese de substâncias bioativas, além da extração, isolamento e purificação de compostos naturais utilizando técnicas cromatográficas clássicas. Também são realizadas avaliações preliminares de bioatividade, empregando o bioensaio com Artemia salina como modelo.
Responsável: Prof. Pedro Gregório Vieira Aquino
Contato: pedro.aquino@ufape.edu.br
Laboratório de Parasitologia (LaPar)
No Laboratório de Parasitologia (LaPar) é realizado o diagnóstico de parasitos de importância médico-veterinária que acometem animais de produção, pets e animais silvestres, assim como a identificação de vetores. Além disso, são realizados testes de resistência a fármacos em populações de parasitos intestinais e carrapatos.
O LaPar, além de oferecer o serviço de diagnóstico em parasitologia, apoia a realização de pesquisas realizadas por discentes de graduação e pós-graduação (mestrado, doutorado e pós-doutorado), contribuindo para a formação de recursos humanos.
Responsáveis: Profa. Gílcia Aparecida de Carvalho/ Prof. Rafael Antonio do Nascimento Ramos
Contato: gilcia.carvalho@ufape.edu.br/rafael.ramos@ufape.edu.br
Laboratório de Pesquisa em Imunologia e Microbiologia
No Laboratório de Pesquisa em Imunologia e Microbiologia (LAPEMI) são realizadas atividades de isolamento, identificação e caracterização molecular de patógenos de interesse para a medicina veterinária, com destaque para os agentes bacterianos contaminantes de produtos de origem animal e de importância em saúde pública.
O LAPEMI também realiza pesquisas para o desenvolvimento de insumos e testes imunológicos para vacinas veterinárias e para o desenvolvimento de testes rápidos utilizados na detecção de patógenos de interesse veterinário e saúde pública.
Responsável: Prof. Marcelo Mendonça
Contato: marcelo.mendonca@ufape.edu.br
Laboratório de Sanidade de Ruminantes
No Laboratório de Sanidade de Ruminantes (LASAR) são realizadas atividades voltadas à identificação e prevenção de enfermidades em ruminantes, com foco em patologia clínica, diagnóstico de doenças, estudos de plantas tóxicas e saúde neonatal. O laboratório também atua na análise de parâmetros hematológicos e bioquímicos, contribuindo para o manejo sanitário e nutricional, promovendo a prevenção de doenças e o bem-estar animal.
Responsáveis: Prof. Luiz Carlos Fontes Baptista Filho/Profa. Taciana Rabelo Ramalho Ramos
Contato: luiz.baptista@ufape.edu.br/taciana.rabelo@ufape.edu.br
Av. Bom Pastor, s/n
Boa Vista
CEP: 55292-278
Garanhus – PE
Universidade Federal do Agreste de Pernambuco
Desenvolvimento: Fábrica da Palavra